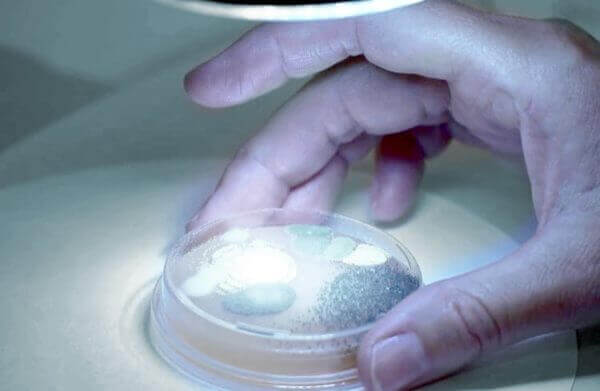

Dansk Miljørådgivning A/S (DMR A/S) har stor grund til at juble i disse år. Rådgivningsvirksomheden med hovedkontor i Ry i Skanderborg kører derudad med en så stærk vækst på både top- og bundlinje, at de fleste danske virksomheder blegner af misundelse. DMR har fordoblet sin omsætning over en fireårig periode og er i 2018 blevet kåret af Dagbladet Børsen som Gazellevirksomhed.
Væksten er primært sket indenfor Dansk Miljørådgivnings to forretningsområder, jord- og grundvand og geoteknik. Derudover har DMR udvidet deres arbejdsområder til også at omfatte arbejdsmiljørådgivning og støj/akustik. Opbygningen af et skimmelsvampslaboratorium, der foretager skimmelsvamp- og bygningsforureningsundersøgelser i hele Danmark, har også bidraget til at øge indtjeningen. Den store efterspørgsel efter Dansk Miljørådgivnings produkter og ydelser har resulteret i en geografisk spredning af væksten. Således har DMR i dag ca. 135 medarbejdere fordelt på 13 kontorer rundt omkring i Danmark og tre kontorer i Norge.
Dygtige medarbejdere og en stærk virksomhedskultur
Kontorleder i Dansk Miljørådgivning A/S, Jens-Ole Petersen, er ikke i tvivl om, hvem der er ansvarlige for succesen.
– Vores høje og markante vækstrater gennem de sidste fire år er først og fremmest et resultatet af dybt engagerede og fagligt dygtige medarbejdere. De fortjener masser af ros, blomster og tak for deres enorme indsats. De har trukket det store læs, og vi kunne ikke have gjort det uden dem, understreger Jens-Ole Petersen.
Årsagen til de høje vækstrater er ifølge Jens-Ole Petersen begunstiget af, at mange af Dansk Miljørådgivnings forretningsområder ligger indenfor vækstmarkeder og en travl byggebranche. Men uden dygtige og engagerede medarbejdere og et konstant fokus på at realisere og pleje DMR´s tre virksomhedsværdier; kundetilfredshed, medarbejdertrivsel og faglig viden og stolthed, ville det ikke kunne lade sig gøre at styre skibet sikkert i mål og holde alle mand inden borde.
– Det er usædvanligt at finde et rådgivende ingeniørfirma i Danmark, der har præsteret de vækstrater, som vi har gjort. Det er unikt, og vi har gjort det rigtig godt. En af forklaringerne er, at hele vores virksomhedskultur er bygget op omkring Dansk Miljørådgivnings værdier. Når vi siger, at vi leverer kvalitet, så leverer vi kvalitet. Og når vi for eksempel siger, at kunden er i centrum, så ER kunden i centrum. Det er ikke bare tomme ord. På samme måde sætter vi alle sejl ind på at skabe gode arbejdsvilkår, ligesom vi aktivt har fokus på hele tiden at styrke vores medarbejders kompetencer og faglige viden, siger Jens-Ole Petersen.

Succes med decentral beslutningsstruktur
Til forskel fra mange andre danske virksomheder har DMR en decentral beslutnings- og ledelsesstruktur. Det betyder blandt andet, at medarbejderne har masser af ansvar og frihed til at træffe beslutninger.
– Vi driver ikke moderne ledelse med rundbordspædagogik og centralisering af beslutningerne. Vi vil hellere være hurtige på aftrækkeren og kunne træffe beslutningerne ude på kontorerne, hvor vi er tæt på kunderne. Vores decentrale struktur er en del af vores virksomheds DNA. Vi giver medarbejderen ansvarsbeføjelser og frihed til at træffe beslutninger, og det er sikkert med til at forklare, at det lykkedes for os at beholde vores dygtige medarbejdere år efter år, siger Jens-Ole Petersen, der selv har været ansat i Dansk Miljørådgivning siden 1998.
Building Network åbner nye døre
Dansk Miljørådgivning kører primært en digital markedsføringsstrategi, hvor de har synliggør sig på internettet. Muligheden for at finde nye kundeemner på Sjælland og i Hovedstadsområdet fik DMI til at melde sig ind i det landsdækkende erhvervsnetværk Building Network, som de fik kendskab til i forbindelse med et netværksarrangement omkring den kommende Femernbælt.
– Vi laver 2000-3000 opgaver om året i hele Danmark, og vores portefølje er sammensat af forskellige typer små og store opgaver. En stor del af vores kunder handler ind hos os igen og igen. Selvom vi har mange gengangere er vi nødsaget til at gribe fat i nogle potentielle kunder, hvis vi skal holde væksten kørende. Vi fandt ud af, at Building Network kunne åbne dørene til de aktører, der er på de store- og mellemstore byggeprojekter på Sjælland og i Hovedstadsområdet, så vi valgte at melde os ind for tre år siden. Og det har vi ikke fortrudt.

Synlighed gennem netværk betaler sig
Selvom det kan være svært at måle og udpege hvilke opgaver, der er resultatet af medlemskabsskabet i Building Network, er Jens-Ole Petersen ikke i tvivl om, at det betaler sig for DMR at møde op og synliggøre sig selv på Building Network konferencer.
– Building Network har været med til at åbne vores øjne for nye kundegrupper. Selvom vi primært synliggør os på internettet, handler synlighed i dag også om at mødes og tale sammen ansigt til ansigt med nye potentielle kunder. Og det er en af styrkerne ved Building Network. Dels bliver vi præsenteret for nye indlægsholdere, der kommer og fortæller om deres virksomhed og nye kommende projekter. Dels har vi mulighed for at netværke og udveksle visitkort og få en en-til-en-samtale med oplægsholderne, siger Jens-Ole Petersen.
Åbner nye kontorer i ind- og udland
Når Dansk Miljørådgivning næste gang lukker årsregnskabet, forventer den succesfulde rådgivningsvirksomhed igen at kunne fremvise imponerende væksttal på både top- og bundlinje. Foreløbig er der ingen planer om at skrue ned for dampen.
Målet er at være 200 medarbejdere i 2020 fordelt på 20 kontorer i Danmark og Norge. Sverige og Nordtyskland er også i sigtekornet.
– Vi oplever meget høje vækstrater i Norge, og vi undersøger mulighederne for at udvide vores forretninger i nabolande som Sverige og i Nordtyskland. I det hele tager tilsiger markedskonjunkturerne og de udviklingspotentialer, vi ser indenfor vores forskellige arbejdsområder, at det burde kunne lade sig gøre for Dansk Miljørådgivning at fortsætte den gode kurs med vækstrater på 15-20 procent om året frem til 2020. Det er i hvert fald målet, afslutter en tilfreds og glad Jens-Ole Petersen.


